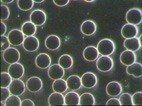
Healthy Blood Sample

Blood Sample A
Basic Consultation (Online)
£140
What's Included:
- Intake forms and food diary
- Initial consultation (60 mins)
- Template guide notes on dietary and nutritional advice
This option does not include any additional appointments
Follow Up Consultation
£70*
What's included:
- 30 minutes appointment (if within 3 months of initial consultation)
- Updated guide notes based on presenting symptoms
*60 minutes consultation required if longer than 3 months since initial consultation
Initial Consultation
£295
What's included:
- Intake forms and food diary
- Initial consultation 60 minutes
- Clinicians professional research 2+ hours
- Bespoke written report with dietary and lifestyle recommendations
- Recommended nutritional supplements and/or herbal medicine
This option includes WhatsApp / email messaging with any questions and queries but does not include Follow-Up Consultation charged at £295
Additional Benefits:
Upgrade your consultation to include
- 50% off Dry Blood Analysis (RRP £149)
- 50% off Live Blood Analysis (RRP £160)
If Live Blood Analysis booked, appointment time will increase to 90 minutes
Follow-Up Consultation
£295
What's included:
- Follow-Up Consultation 60 minutes
- Presenting symptoms, program wins and program challenges discussed
- Updated bespoke report to include diet, nutrition and lifestyle recommendations where applicable
Additional Benefits:
Upgrade your consultation to include
- 50% off Dry Blood Analysis (RRP £149)
- 50% off Live Blood Analysis (RRP £160)
If Live Blood Analysis booked, appointment time will increase to 90 minutes
The Philosophy of Naturopathy
"Let food be thy medicine and medicine be thy food" Hippocrates.
Naturopathy is a system of medicine that seeks to promote positive health by removing obstructions to vitality, these can be physical and emotional toxins, while supporting the body's inherent self-healing tendency by providing the correct micro and macro nutritional elements to restore health, harmony and wellness. The body is astonishingly resilient when given the right nutritional tools.
About me
My interest in health began at an early age. I was brought up in New Zealand where the air is clear and the lifestyle is outdoors. As a child I would ride everywhere on my bike, pick pippies (Clams for those in the UK) off the beach for dinner, take trips to orchards to purchase organic fruits and vegetables, weekends were spent on the beach and at the pools or camping near lakes. We used to regularly visit the natural healing, mineral rich hot spring pools. My holidays were spent on my Uncle Don's dairy farm in a place called Teawamutu (te-awa-mutu), in the middle of the beautiful New Zealand native countryside where we would get up 5.30am and ride on the back of a tractor to help heard in the cows to the milking shed. My job was to attach the suction pads to the teats and afterwards to help hose down and sweep up the cow pats in the milking yard. Oh yes, I loved every minute of my childhood in New Zealand. My school had an outdoor swimming pool where the teacher would allow the class to take a swimming break if it got too hot, so we always made sure we had out togs at the ready for such occasions. In fact, outdoor sports was the a key component to education.
Then, I happened to spend a few years at school in England in my teenage years, where I attended an inner city London Secondary School. The lifestyle difference was quite shocking to me. My first impression was the pale complexion of the students and how they looked unwell overall compared to NZ students. I was also quite intrigued at how every lunchtime an ice cream van arrived at the school gates, blasting twinkling music, which corralled the students to form a line to purchase their ice creams and sweets on a daily basis. This combined with the 'corner shop' offering crisps with every flavour you could imagine under the sun. In New Zealand we only had three favours - plain, chicken or salt and vinegar! There was also school dinners, which we did not have in New Zealand schools, only our own packed lunches, so seeing students eating chips and baked beans and fish fingers and spotty dick with custard for dessert for lunch was intriguing . I also noticed that most of the students did all they could to opt out of PE lessons. And when changing for PE, the shapes of the girls were completely different to the shapes of the girls in New Zealand. They were more heavy on the thighs and carried more weight in general. I tried to continue my 'kiwi' lifestyle as best I could whilst in London and I would put on my jogging shorts and go for a run. Well, I believe I must have been the first person, or at least first 14 year old to ever jog the streets of London! I discovered no one went jogging, as I would get pointed and jeered at by people. Hard to imagine now but that is exactly what used to happen. The next day at school kids who had seen me would laugh and ask me why I was running in my shorts around the streets. I was equally bemused as I couldn't understand why no-one was running on the streets, which in New Zealand was common to see. I did not let them put me off as I always felt so good after a run. But even to this day I am known as that girl who used to run around the streets.
So getting back to how my journey started into health, this time I spent in the UK really opened my eyes as to how different lifestyles changed body shapes. Also there was an element of unhappiness, complacency and sadness I noticed amongst the students in London compared to New Zealand who were outgoing, energetic and enthusiastic. But I do recall feeling empathy for students who appeared to be really angry and often aggressive at times, quite often directed at me as I was the odd one out with my kiwi accent, tan and odd ways. I used to think, gosh if this life is all I had known, I would probably feel and be the same way too. The long rows of brown brick houses all joined together, no beautiful beaches or stunning scenery nearby, sunshine was limited, winters were very cold, life was very much indoors in comparison.... and I remember thinking then that perhaps the diet and lack of exercise played a role in that. I certainly found it challenging being in a confined space with limited freedom to express oneself.
After my school experience in the UK finished I was travelling back and forth to New Zealand with family now on both sides of the world. As a young adult I was attracted to the hustle and bustle London life, which had drawn me in. The history, the rich multi-cultural society, the nightlife, the new friends I had made, Europe on the door step and the abundance of job opportunities. After working for a holiday firm, where I was lucky enough to spend a great deal of time in Spain I started working in Central London for a large corporation as Business Development Manager for a travel Bureau De Change company. Excited to be working in Central London, but I hadn't quite appreciated the daily slog on the underground each day, the 9 to 5 commitment that ended up being more 9 to 8 would catch up on me. The skipping breakfasts, the lunches on the go, the increase in coffee, the afterwork drinks at the trendy wine bars, the late nights, the 'all' nights, the up early's. Gradually I noticed my energy was depleting. The extra sleep at the weekends was no longer the antidote. The noise of Central London began to sound much louder each day, sirens began piercing at my ears, sleeping on the trains became normal, grabbing sweet treats to keep me going became habit... I was not listening to my body signs that I was way off track with my lifestyle and eating habits. I got sick, ended up with a temperature of 106 for three days, in the isolation ward in a tropical diseases hospital after a trip to Mauritius as it was concluded I must have caught some unknown virus!
Well after being delirious for three days, I went home after seven days and basically never seemed to recover. I'd had an upper respiratory infection and ulcers in my throat had left scars that would ultimately cause my throat to suddenly seize up unless I could drink some water immediately. I would carry bottled water with me everywhere to avoid the episodes. That was also a first, as people were not drinking bottled water at that time. I returned to work, with what felt like on 20% battery power. By the end of the day it would be 5%. I would simply fall into bed as soon as I was home. At work one day I noticed so much of my hair was on the floor around my chair. I panicked and booked in that afternoon to see a Trichologist. She took one look at the root of one of my falling out hairs and announced with certainty I had iron deficiency as confirmed by the curved shape. She also weighed me and said I was underweight. I had always been so athletic and full of health. I realised at this point I was struggling to hold together my job, but my health had to be my priority. This fatigue had been going on for over a year and various doctors simply told me I had Yuppy Flu and there was nothing they could do to help except maybe I should take some anti-depressants. These I never took, I told the doctors yes I'm feeling low due to low energy but I'm not depressed. I was now wasting away and going half bald. Enough was enough. I decided that moment to go home to New Zealand. My sister was studying Naturopathy in New Zealand at the time and she organised for me to see a top Naturopath in Auckland. At my appointment with him he performed Live Blood Analysis and showed me iron deficient cells and a low immunity. I was put on nutrients and herbs and diet changes. This is where my life charged course. Within 6 weeks I was running to the top of One Tree Hill (circa 5 miles from where I was living), my energy had returned, I found my smile again and was happy in my body once again. I decided there and then that I wanted to study Naturopathy and Live Blood Analysis and help people the way I had been helped. Well that was 22 years ago now and that is exactly what I have been doing.

Initial Consultation
£140
What's included:
- Jump on a call and we will talk over your health concerns
- Initial consultation 60 minutes
- Dietary, nutritional and lifestyle recommendations
This option does not include any additional appointments.
Additional Benefits:
Upgrade your consultation to include
- 50% off Dry Blood Analysis (RRP £149)
- 50% off Live Blood Analysis (RRP £160)
Optimum Health Package
£595
What's included:
- Intake forms and food diary
- Initial consultation 60 minutes
- Clinicians professional research 2+ hours
- Bespoke written report with dietary and lifestyle recommendations
- Recommended nutritional supplements and/or herbal medicine
Additional Appointments:
- Follow up appointment (60 mins) with updated plan
- 2 x 15 minute support appointments via telephone
- 1 x laboratory test results review
Additional Benefits:
- Includes Dry Blood Analysis (£149)
- 50% off Live Blood Analysis (RRP £160)
If Live Blood Analysis booked, appointment time will increase to 90 minutes.
Basic Consultation
£140
What's Included:
- Intake forms and food diary
- Initial consultation 60 minutes
- Guide notes on dietary and nutritional advice, based on presenting symptoms
This option does not include any additional appointments
Follow Up Consultation
£70*
What's included:
- 30 minutes appointment (if within 3 months of initial consultation)
- Updated guide notes based on presenting symptoms
*60 minutes consultation required if longer than 3 months since initial consultation
Naturopathic Consultations
Initial Consultation - 60 mins - £140
Follow-up Consultation - 30 mins - £70
Follow-up Consultation - 60 mins - £140
..with Diagnostic Test Results
Wellness Review Consultation - 30 mins - £70
Mini Telephone Consultation - 15 mins - £35
Diagnostic Test Results - 30 mins - £70
Note: If you have a query or question between consultations, I am always available on WhatsApp or Email..
Express Online Consultation
20 minutes
This consultation is best if you have a question you would like to talk through with a Naturopath? This session is perfect for advice and supplement recommendations for acute symptoms. Please note this is not a full assessment and is designed for acute symptoms or asking a specific question only.
"Your immune system needs you right now"
DETOX
NUTRITION
LIFESTYLE
New title
Seed Based Nutrition
I now include Seed Nutrition into my practice. All life and nutrients begins in the seed. Each seed contains more nutrients per-part than what it eventually grows into. Seed based nutrient extracts, straight from the source, can provide your body with super dense nutrients to super charge your health.
“There is not one second left for gears to be switched and to replace the current killer vaccines”
Dr Geert Vanden Bossche PhD
Renown Vaccine Expert and Immunologist
Interview - Immediately Halt Global Covid 19 Vaccinations
Attitude
"Before you can help heal someone, ask if they are willing to give up the things that made them sick"
Hippocrates
Are you will to take charge of your health?
"The reality of what is going on with the covid19 pandemic, is so apparent that no honest witness can deny the global crime that is taking place".
David Sorensen,
Stop World Control
“Everything is out in the open but most people don't see it because they don't believe that such a thing is possible”
Reiner Feullmich,
Trial Lawyer
Speaker
WE LOVE TO HELP
We love to help people enhance their wellbeing..
If you're looking to improve your overall health, you've come to the right place.
Browse the site, you'll find plenty of naturopathic health advice on many common health conditions and wellness goals. There is a FREE Online Health Check-Up to help get you started on the journey to better health. Click Caroline Mansfield to book an online naturopathic consultation today.
A Healthy Outside Starts Inside
Symptoms are your body's way of telling you something needs to change, be replaced or be removed...
Enhance your wellbeing
Our philosophy
BOOST YOUR VITALITY
Online Consultations
DIAGNOSTIC TESTS
HEALTH PROGRAMS
MAKE BETTER CHOICES
- Nutritional deficiencies
- Organ/system dysfunctions
- Certain biochemical imbalances
- Immune system imbalances
- Micro-organisms /yeast / bacteria
Naturopathic Medicine
Naturopathic Medicine is a distinct health care profession, with emphasis on prevention, treatment, and optimal health through methods that encourage the individual’s inherent self-healing process.
Naturopathic Medicine
Naturopathic Medicine is a distinct health care profession, with emphasis on prevention, treatment, and optimal health through methods that encourage the individual’s inherent self-healing process.
- Online naturopathic consultations from the comfort and convenience of your own home.
- Registered professional health care
- Personalised treatment plans
- Practitioner prescribed supplements and vitamins
- Functional medicine pathology testing
- Diet sheets
Start living the life you deserve to live
A Healthy Outside Starts From The Inside
Working with a naturopath requires us to be partners in your health..
Online Consultations
Start living the life you deserve to live
A Healthy Outside Starts From The Inside
hot flushes, anxiety, weight gain, insomnia
Online Consultation
£40
Online Consultation
£160
"You can help your immune system by following a healthy, balanced diet filled with lots of fruits and vegetables".
Discovery Call
No Charge
Online Consultation
£180
Online Consultation
£60

coronavirus
The Philosophy of Naturopathy
"Let food be thy medicine and medicine be thy food" Hippocrates.
Naturopathy is a system of medicine that seeks to promote positive health by removing obstructions to vitality, these can be physical and emotional toxins, while supporting the body's inherent self-healing tendency by providing the correct micro and macro nutritional elements to restore health, harmony and wellness. The body is astonishingly resilient when given the right nutritional tools.